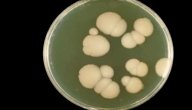
أعراض الكانديدا

محتويات
- ١ المهبل
- ٢ ما هو كانديدا المهبل
- ٣ هل كانديدا المهبل معدية
- ٤ أعراض كانديدا المهبل
- ٥ أسباب كانديدا المهبل
- ٦ تشخيص كانديدا المهبل
- ٧ علاج كانديدا المهبل
- ٨ علاجات منزلية لكانديدا المهبل
- ٩ الوقاية من كانديدا المهبل
- ١٠ الدورة الشهرية عند الاصابة بكانديدا المهبل
- ١١ تأثير كانديدا المهبل على الحامل
- ١٢ فيديو عن علاج كانديدا المهبل
المهبل
عبارة عن عضلة سميكة ومرنة يبلغ طولها 9 سانتيميتر تقريبًا، ويغطي هذه العضلة طبقة من النسيج الضام والذي يحتوي على الأوعية الدموية والقنوات اللمفاوية والألياف العصبية، ويقع المهبل أمام المستقيم وخلف المثانة، وتتصل المنطقة العليا له بعنق الرحم، ويكون مغلق عند النساء العذارى بطبقة رقيقة من الأنسجة تسمى غشاء البكارة، وهذا الغشاء مغطى بالشفرين الكبيرين، وللمهبل العديد من الوظائف ومنها؛ استقبال العضو التناسلي الذكري أثناء الجماع ومرور الطفل أثناء الولادة وتصريف إفرازات الدورة الشهرية، وقد يصاب المهبل بالعديد من الأمراض كالالتهابات البكتيرية أو الأورام السرطانية أو كانديدا المهبل، وخلال هذه المقالة سيتم التحدث عن كانديدا المهبل.[١]
ما هو كانديدا المهبل
الفطريات تعيش بشكلٍ طبيعي في أماكن عديدة من جسم الإنسان كالفم أو القنوات الهضمية أو المهبل، وخاصةً فطريات الخميرة، وتكون موجودة بشكلٍ متوازن، وعادةً قد لا تؤدي إلى حدوث أي مشاكل، ولكن حدوث خلل في توازن هذه الفطريات سيؤدي إلى الإصابة ببعض الأمراض كمرض كانديدا المهبل -والذي يسمى أيضًا بداء المبيضات- وهو عبارة عن التهاب فطري تصاب به النساء عند فرط نمو الفطريات الموجودة في المهبل، وتجدر الإشارة إلى أن هذا المرض شائع الحدوث، وقد تصاب به النساء عدة مرات خلال فترة حياتهم، ويتميز بحدوث حرقة واحمرار وخروج إفرازات بيضاء من المهبل.[٢]
هل كانديدا المهبل معدية
مرض كانديدا المهبل لا يعتبر من أحد الأمراض المنقولة بالاتصال الجنسي، ولكنه ما زال معديًا، ويمكن أن تنتقل الفطريات المسببة لهذا المرض أثناء الجماع من المهبل أو أثناء ممارسة الجنس الفموي، ومن الممكن أن تنتقل عن طريق تقبيل شخص مصاب بالقلاع الفموي، وأيضًا قد تنتقل هذه الفطريات من الأم إلى الطفل أثناء الولادة وستؤدي إلى إصابته بطفح جلدي، وفي بعض الحالات قد تنتقل الفطريات إلى الطفل أثناء الرضاعة الطبيعية، وخاصةً عند فرط نمو تلك الفطريات في منطقة الثدي، وتجدر الإشارة إلى أن هذه الفطريات لا تنتقل من شخصٍ لآخر عن طريق رذاذ الهواء أو استخدام حمام شخص مصاب بالعدوى.[٣]
أعراض كانديدا المهبل
قد يحدث فرط نمو الفطريات في الأماكن الرطبة من الجسم كالفم أو الحلق أو فتحة الشرج أو الإبطين أو تجويف الأنف أو السرة أو القنوات الهضمية أو الأظافر أو داخل الأذنين أو بين الأصابع أو المهبل، وفرط نمو تلك الفطريات بالمهبل سيؤدي إلى حدوث مرض كانديدا المهبل، وستظهر العديد من الأعراض عند الإصابة بهذا المرض، وسيتم توضيحها، وهي كالآتي:[٤]
- حكة في المهبل، وفي بعض الأحيان قد تكون شديدة.
- إفرازات بيضاء وسميكة وعديمة الرائحة من المهبل.
- تهيج الجلد حول فتحة المهبل، واحمرار وتورم المهبل.
- حدوث نزيف خفيف.
- الشعور بألم في المهبل، وخاصةً أثناء الجماع وأثناء الدورة الشهرية.
- الشعور بألم أثناء التبول.
- خروج رائحة غير اعتيادية للمهبل.
أسباب كانديدا المهبل
يحتوي المهبل على بكتيريا وفطريات تكون متواجدة بشكلٍ متوازن فيه، وتساعد على قتل الكائنات التي تسبب الضرر للمهبل، ولكن في بعض الأحيان قد يحدث خلل في توازن الفطريات وبالتالي الإصابة بمرض كانديدا المهبل، ويوجد العديد من الأسباب التي تؤدي إلى حدوث هذا المرض، وسيتم توضيح هذه الأسباب، وهي كالآتي:[٥]
- التغيرات الهرمونية: التغيرات الهرمونية أثناء الحمل أو أثناء الرضاعة الطبيعية أو عند انقطاع الطمث أو عند تناول حبوب منع الحمل قد تؤدي إلى حدوث خلل في توازن الفطريات في المهبل.
- مرض السكري: قد يؤدي إلى زيادة مستوى السكر في الأغشية المخاطية المبطنة للمهبل وبالتالي حدوث فرط في نمو الفطريات التي تسبب كانديدا المهبل، وخاصةً عندما يكون مرض السكري غير متحكم به.
- المضادات الحيوية: هذه الأدوية قد تعمل على قتل البكتيريا الصحية الموجودة بالمهبل وبالتالي الإصابة بهذا المرض.
- غَسُول المهبل: استخدام الغسولات المهبلية قد يؤدي لحدوث خلل في توازن الفطريات في المهبل.
- ضعف المناعة: الأمراض التي تؤدي لضعف في جهاز المناعة كمرض نقص المناعة المكتسبة قد يؤدي إلى حدوث فرط في نمو الفطريات في المهبل.
- ممارسة الجنس: على الرغم من أن مرض كانديدا المهبل لا يعتبر من الأمراض التي تنتقل بالاتصال الجنسي، ولكن قد ينتقل من شخصٍ لآخر عن طريق ممارسة الجنس.
تشخيص كانديدا المهبل
تشخيص مرض كانديدا المهبل هام جدًا في تحديد طرق العلاج المناسبة، وذلك لأن الأعراض التي تظهر عند الإصابة بهذا المرض مشابهة للأعراض التي تظهر عند حدوث بعض الأمراض الأخرى كالالتهابات البكتيرية في المهبل أو الأمراض التي تنتقل بالاتصال الجنسي والتي تستلزم علاجات أخرى مختلفة[٦]، وسيقوم الطبيب بإجراء العديد من الاختبارات للتشخيص، وسيتم توضيحها، وهي كالآتي:[٧]
- السؤال عن التاريخ الطبي: سيقوم الطبيب بسؤال المرأة المصابة عما إذا كانت قد تعرّضت لالتهابات مهبلية سابقة أو عما إذا كانت قد أصيبت سابقًا بالأمراض التي تنتقل عبر الاتصال الجنسي أم لا.
- اختبار فحص الحوض: خلال هذا الاختبار سيقوم الطبيب بفحص الأعضاء التناسلية، وذلك للبحث عن علامات العدوى، وأيضًا خلال هذا الاختبار قد يقوم الطبيب بوضع أداة خاصة في المهبل لإبقائه مفتوحًا، ومن ثم سيقوم بفحص المهبل من الداخل وفحص عنق الرحم.
- اختبار تحليل الإفرازات المهبلية: قد يقوم الطبيب بأخذ عينة من الإفرازات التي تخرج من المهبل ومن ثم يقوم بإرسالها إلى المختبر لتحليلها، وذلك لمعرفة نوع الفطريات التي تسبب هذا المرض، وتجدر الإشارة إلى أن معرفة نوع الفطريات يساعد على تحديد العلاج المناسب.
علاج كانديدا المهبل
عادةً ما يساعد استخدام الأدوية على علاج مرض كانديدا المهبل، ولكن يختلف علاج الحالات الخفيفة من هذا المرض عن علاج الحالات الشديدة، ويوجد العديد من الطرق التي تساعد على العلاج، وسيتم توضيح طرق علاج كل حالة من تلك الحالات، وهي كالآتي:[٧]
علاج الحالات الخفيفية
عندما يؤدي مرض كانديدا المهبل إلى حدوث أعراض خفيفة إلى معتدلة وعندما لا يتكرر حدوثه، فسيقوم الطبيب باستخدام العديد من الطرق التي تساعد على شفائه، ولكن يجب مراجعة الطبيب إن لم تساعد هذه الطرق على شفاء الأعراض أو إن ظهرت الأعراض مرةً أخرى خلال شهرين، وسيتم توضيح هذه الطرق، وهي كالآتي:
- العلاج المهبلي الذي يؤخذ على المدى القصير: عادةً ما يساعد أخذ الأدوية المضادة للفطريات كدواء الميكونازول أو دواء التيركونازول لمدة من ثلاثة إلى سبعة أيام على علاج هذا المرض، وتجدر الإشارة إلى أن هذه الأدوية متوفرة على شكل أقراص أو كريمات أو مرهم أو تحاميل، وبعضها يحتاج إلى وصفة طبية والبعض الآخر لا يحتاج.
- الأدوية التي تؤخذ مرةً واحدةً عن طريق الفم: تساعد هذه الأدوية كدواء الفلوكونازول على علاج هذا المرض، وفي بعض الأحيان وعندما تكون الأعراض حادة قد يتم أخذ جرعتين لثلاث من هذه الأدوية خلال ثلاث أيام، وتجدر الإشارة إلى أنه لا ينصح باستخدام هذه الأدوية عندما تكون المرأة حامل.
علاج الحالات الشديدة
عندما تكون الأعراض المصاحبة لمرض كانديدا المهبل شديدة، وعند الإصابة بهذا المرض بشكلٍ متكرر، فسيقوم الطبيب باستخدام العديد من الطرق الأخرى لعلاج هذا المرض، وسيتم توضيح هذه الطرق، وهي كالآتي:
- العلاج المهبلي الذي يؤخذ على المدى الطويل: قد يقوم الطبيب بوصف أدوية مضادة للفطريات تؤخذ يوميًا لمدة أسبوعين، وبعد ذلك سيتم أخذ هذه الأدوية مرةً واحدةً كل أسبوع لمدة ستة أشهر.
- الأدوية التي تؤخذ عدة مرات عن طريق الفم: قد يقوم الطبيب بإعطاء المريض جرعتين أو ثلاث جرعات من الأدوية المضادة للفطريات والتي تؤخذ عبر الفم، وتجدر الإشارة إلى أنه يمنع تناول النساء الحوامل لهذه الأدوية.
- العلاج المقاوم للأزول: قد يقوم الطبيب باستخدام حمض البوريك والذي يتم إدخاله إلى المهبل عن طريق كبسولة لعلاج الحالات الشديدة من المرض، وتجدر الإشارة إلى أنه يجب تجنّب تناول هذا الدواء عن طريق الفم لأنه قد يكون قاتلًا.
علاجات منزلية لكانديدا المهبل
في الكثير من الأحيان يمكن أن يساعد استخدام بعض العلاجات المنزلية كبعض الأدوية التي لا تستلزم وصفة طبية أو العلاجات البديلة على شفاء كانديدا المهبل، وأيضًا يوجد العديد من العلاجات المنزلية، وسيتم توضيح جميع هذه العلاجات، وهي كالآتي:[٨]
- زيت شجرة الشاي: يساعد استخدام هذا الزيت على علاج مرض كانديدا المهبل، وذلك لاحتوائه على العديد من المواد المضادة للفطريات، ويمكن أخذ هذا الزيت عن طريق تحاميل مهبلية، ولكن في بعض الأحيان قد يؤدي استخدام هذه التحاميل إلى تهيّج جلد وجدران المهبل، كما ويمكن استخدام هذا الزيت عند خلط من 3 إلى 5 قطرات منه مع زيت جوز الهند ومن ثم وضعه على سدادة قطنية ووضعها في المهبل لامتصاصه، ويجب تغيير السدادة القطنية بانتظام، وتجدر الإشارة إلى أن بعض الأشخاص قد يعانون من رد فعل تحسسي لزيت شجرة الشاي، ولذلك يجب قبل استخدامه وضع قطرات مخففة من هذا الزيت على اليد والانتظار لمدة من 12 إلى 24 ساعة لرؤية ما إذا كان هناك تفاعل أم لا.
- مكملات البروبيوتيك: تعمل هذه المكملات على إعادة التوزان الطبيعي للبكتيريا والفطريات في المهبل، ويمكن أخذها عن طريق الفم أو المهبل، ويساعد أخذ هذه المكملات مرةً واحدة كل ليلة لمدة أسبوع ومن ثم مرةً واحدةً كل 3 أيام على علاج هذا المرض، كما ويمكن استخدامها مرةً واحدةً كل أسبوع بشكلٍ مستمر للوقاية من تكرار حدوث الإصابة مستقبلًا، وتجدر الإشارة إلى أن استخدام مكملات البروبيوتيك يساعد على علاج 87% من حالات الإصابة بهذا المرض.
- الزبادي الطبيعي: يحتوي الزبادي الطبيعي غير المحلّى على بكتيريا صحية تسمى البروبيوتيك والتي تساعد على إعادة توازن البكتيريا والفطريات في الجسم، ويمكن استخدام الزبادي الطبيعي عن طريق تناوله، كما يمكن تطبيقه بشكلٍ موضعي على الفرج أو حول المهبل، وأيضًا يمكن إدخاله إلى المهبل.
- زيت جوز الهند: يحتوي هذا الزيت على خصائص مضادة للفطريات، ويمكن استخدامه داخليًا وخارجيًا ويساعد على تخفيف أعراض مرض كانديدا المهبل.
- الثوم: يحتوي على خصائص مضادة للفطريات ومضادة للبكتيريا، وتناول الثوم ليس له تأثير على مستوى الفطريات في المهبل، وبعض النساء يقومون بوضع الثوم داخل المهبل لعلاج هذا المرض، ولكن لا يوجد دليل علمي على فاعلية هذه الطريقة، كما ويجب تجنب وضع الثوم في المهبل عند النساء صاحبات البشرة الحساسة، وذلك لأن وضعه قد يؤدي إلى تفاقم الشعور بالحرقة، وتجدر الإشارة إلى أنه يمكن استخدام بعض الكريمات التي تحتوي على الثوم والزعتر كالكلوتريمازول Clotrimazole في علاج مرض كانديدا المهبل.
- زيت الأوريجانو: يحتوي هذا الزيت على مواد مضادة للفطريات كالثيمول thymol والكرافكرول carvacrol، ويمكن استخدام هذا الزيت عن طريق إدخال كبسولات تحتوي عليه في المهبل ليلًا، وأيضًا يمكن وضعه على سدادة قطنية ومن ثم وضعها في المهبل لامتصاصه، ويجب أن يتم تغييرها كل 2 إلى 4 ساعات، كما ويجب خلط من 3 إلى 5 قطرات من زيت الأوريجانو مع زيت اللوز أو زيت جوز الهند أو زيت الزيتون قبل استخدامه، وذلك لتخفيفه، وتجدر الإشارة إلى أنه يجب اختبار رد الفعل التحسسي لهذا الزيت قبل استخدامه.
الوقاية من كانديدا المهبل
تجنب أسباب الإصابة بمرض كانديدا المهبل يساعد على الوقاية، كما ويساعد ارتداء ملابس داخلية قطنية وغير ضيقة على تقليل خطر الإصابة، وأيضًا يوجد العديد من الطرق الأخرى التي يساعد اتباعها على الوقاية من هذا المرض، وسيتم توضيح هذه الطرق، وهي كالآتي:[٩]
- تجنب ارتداء الجواب الطويلة والضيقة.
- تجنب استخدام الغسول المهبلي، وذلك لأنه يعمل على قتل البكتيريا الصحية الموجودة في المهبل.
- تجنب استخدام المنتجات المعطرة.
- تجنب الاستحمام بالمياه الساخنة جدًا.
- تجنب الإفراط في استخدام المضادات الحيوية، وخاصةً أثناء نزلات البرد.
- تجنب ارتداء الملابس المبللة لفترات طويلة.
الدورة الشهرية عند الاصابة بكانديدا المهبل
الإصابة بمرض كانديدا المهبل أثناء الدورة الشهرية قد يؤدي إلى جعل هذا المرض أكثر شدةً، ولكن هذا الأمر ليس شائعًا، وعادةً ما تصاب النساء بهذا المرض خلال الأيام القليلة التي تسبق فترة الدورة الشهرية، وذلك بسبب التغيرات الهرمونية التي تحدث خلال تلك الأيام والتي تؤدي إلى حدوث خلل في توازن البكتيريا الصحية الموجودة في المهبل، وعند ظهور أعراض هذا المرض فيجب البدء بعلاجه على الفور وقبل بدء الدورة الشهرية، ولكن عند عدم تحسن الأعراض بعد انتهاء الدورة الشهرية فيجب التوجه لنيل الرعاية الطبية.[٣]
تأثير كانديدا المهبل على الحامل
مرض كانديدا المهبل شائع الحدوث أثناء فترة الحمل، وذلك نتيجة التغير الذي يحدث في مستوى الهرمونات خلال تلك الفترة، وتختلف طريقة علاج هذا المرض عند النساء الحوامل عن طريقة علاجه عند النساء غير الحوامل، ولا يمكن استخدام الأدوية المضادة للفطريات التي تؤخذ عبر الفم خلال فترة الحمل، وذلك لأن استخدامها قد يؤدي إلى تعرض الجنين لعيوب خلقية، وأيضًا قد يتم انتقال الفطريات التي تسبب هذا المرض إلى الطفل أنثاء الولادة وستؤدي إلى إصابته بطفح جلدي أو إصابته بالقلاع الفموي أثناء الرضاعة الطبيعية، وتجدر الإشارة إلى أنه يفضل علاج هذا المرض بشكلٍ مبكر أثناء الحمل، وذلك لتجنب حدوث تلك المضاعفات.[٣]
فيديو عن علاج كانديدا المهبل
في هذا الفيديو تتحدث استشارية النسائية والتوليد والعقم وجراحة المناظير الدكتورة أنديرا أبو عناب عن علاج كانديدا المهبل.[١٠]
المراجع[+]
- ↑ "Vagina", www.britannica.com, Retrieved 30-11-2019. Edited.
- ↑ "Yeast Infections", my.clevelandclinic.org, Retrieved 30-11-2019. Edited.
- ^ أ ب ت "Everything You Want to Know About Vaginal Yeast Infections", www.healthline.com, Retrieved 30-11-2019. Edited.
- ↑ "How to Get Rid of a Vaginal Yeast Infection for Good", draxe.com, Retrieved 1-12-2019. Edited.
- ↑ "Vaginal Yeast Infections", www.webmd.com, Retrieved 1-12-2019. Edited.
- ↑ "Overview of Yeast Infection", www.verywellhealth.com, Retrieved 1-12-2019. Edited.
- ^ أ ب "Yeast infection vaginal", www.mayoclinic.org, Retrieved 1-12-2019. Edited.
- ↑ "How to get rid of a yeast infection", www.medicalnewstoday.com, Retrieved 1-12-2019. Edited.
- ↑ "Yeast infection vaginal", www.mayoclinic.org, Retrieved 1-12-2019. Edited.
- ↑ "علاج كانديدا المهبل", youtube.com, Retrieved 06-01-2020.